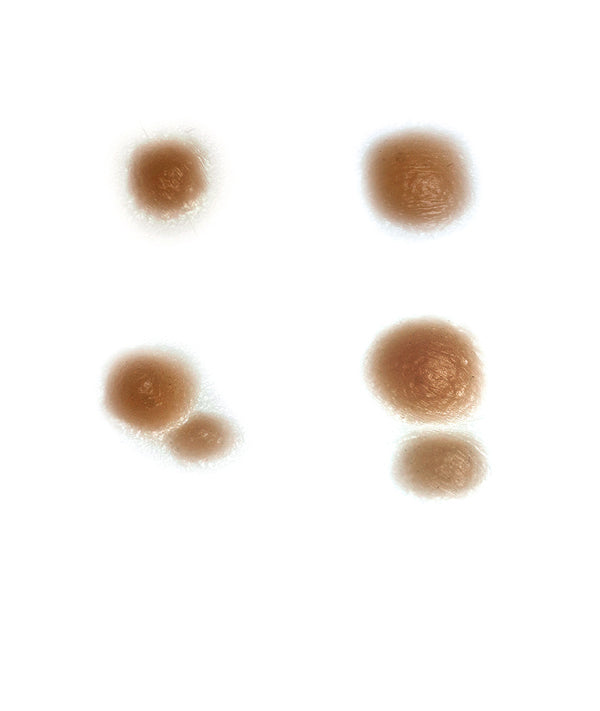

Boil Kit
Boil Kit
Regular price
$99.99 USD
Regular price
Sale price
$99.99 USD
Unit price
per
Shipping calculated at checkout.
SKU:KTCH-13
Boil Kit
This Kit includes 1 of each of the following pieces:
Small Boil CHDE-0377
Medium Boil CHDE-0378
Boil Pair Small CHDE-0380
Boul Pair Large CHDE-0381
Approximate Weight in Grams:
AVERAGE PROCESSING IS 2 DAYS
Couldn't load pickup availability